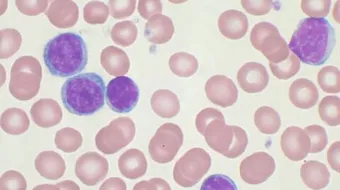
من أعراض سرطان الدم

من أعراض سرطان الدم
سرطان الدمسرطان الدم أو اللوكيميا، ويُعرف أيضاً باسم ابيضاض الدم، وهو أحد أنواع السرطانات التي تُصيب الأنسجة والخلايا الخاصة بإنتاج الدم مثل: نخاع العظم، حيث

سرطان الدم
سرطان الدم أو اللوكيميا، ويُعرف أيضاً باسم ابيضاض الدم، وهو أحد أنواع السرطانات التي تُصيب الأنسجة والخلايا الخاصة بإنتاج الدم مثل: نخاع العظم، حيث يبدأ نخاع العظم عند المصاب بإنتاج خلايا الدم البيضاء الشاذة التي تدخل إلى تيار الدم، وبالتالي فهي تحل محل خلايا الدم السليمة والطبيعية، حيث تزاحمها وتمنعها من القيام بوظائفها بالشكل السليم.
أنواع سرطان الدم
يوجد أكثر من نوع لسرطان الدم، بعضها مزمن وبعضها حاد، فسرطان الدم الحاد ينمو بسرعة، وتصبح الحالة سيئة بدرجةٍ سريعة، وقد تُصبح حياة المريض مهددة؛ لأن نخاع العظم في هذا النوع ينتج كريات دم بيضاء غير ناضجة بأعداد كبيرة، وهذا النوع من السرطان هو النوع الأكثر شيوعاً ويتفرع إلى نوعين؛ وهما: سرطان الدم النقياني الحاد، وسرطان الدم الليمفاوي الحاد، أما سرطان الدم المزمن فهو يتطور بشكلٍ تدريجي وبطيء، وتظهر الأعراض خلال مدة زمنية طويلة، وهو أيضاً نوعان: سرطان الدم النقياني المزمن، وسرطان الدم الليمفاوي المزمن، أما آخر نوع من سرطان الدم فهو سرطان دم الخلية الشعرية الذي يصيب عادةً كبار السن، وهو من الأنواع نادرة الحدوث، ويكون على شكل فقر دم شديد.
أعراض الإصابة بسرطان الدم
- الشعور الدائم بالإعياء والتعب بلا سبب.
- انخفاض وزن الجسم بشكلٍ كبير ومفاجئ، ودون سببٍ واضح ومعروف.
- عدم الرغبة في تناول الطعام باستمرار، وشعور المريض بالامتلاء بمجرد تناول كمية قليلة من الطعام.
- الإصابة بكدمات زرقاء اللون، وانتشارها في الجسم بشكلٍ كبير، بالإضافة إلى سهولة الإصابة بالنزيف.
- كثرة الإصابة بالعدوى وتكرارها.
- الإصابة بنوبات من الحمى والتعرق في أوقات الليل دون سببٍ واضح.
- تورم العقد الليمفاوية، وخصوصاً تحت الإبط وفي الرقبة.
- نزيف اللثة وتورمها.
- الشعور بألم مزعجٍ في البطن، بالإضافة إلى انتفاخه.
أسباب سرطان الدم
لا يوجد سبب معين للإصابة بسرطان الدم، فالسبب الحقيقي للإصابة به غير معروف، لكن لوحظ وجود العديد من المسببات التي تعجل ظهوره، وتزيد احتمالية الإصابة به، ومن أهم هذه المسببات ما يأتي:
- التدخين بكافة أشكاله، سواء تدخين السجائر أو الشيشة.
- التعرض الدائم للأشعة بمستويات عالية.
- التعرض المفرط للمواد الكيميائية، وخصوصاً مادة البنزين التي تدخل في تحضير الصناعات الكيميائية.
- معاناة الشخص من متلازمة خلل التنسج النقوي، بالإضافة إلى معناناته من العديد من الاضطرابات المتعلقة بالدم في جسمه.
- الخضوع للعلاج بأنواع معينة من الأدوية، وخصوصاً أدوية العلاج الكيماوي؛ ومن هذه العلاجات: alkylating agents, etoposide.
المقال السابق: كيفية علاج ثعلبة الشعر
المقال التالي: طرق علاج نحافة الأطفال
من أعراض سرطان الدم: رأيكم يهمنا
0.0 / 5
0 تقييم
